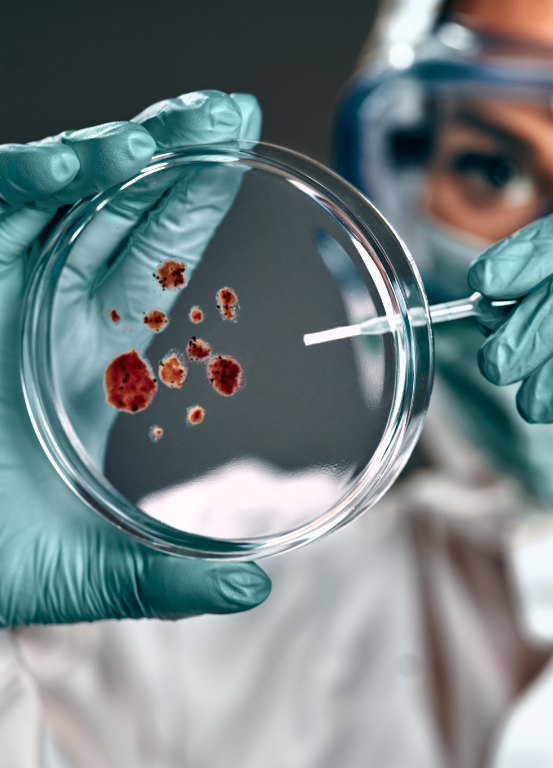
medical technology solutions

KritiKal Solutions is a dynamic force in product engineering, research, development, and an innovative Medtech company that provides comprehensive end-to-end integration of related technologies encompassing all your requirements. It excels in the manufacturing of diagnostic devices, ensures compliance with industry standards and creates innovative applications to meet diverse needs and foster reliability. We have successfully delivered products compliant with EMI/EMC and IEC 60601-1-2 regulatory standards. It has become the global partner for accelerating IT innovation of many Fortune 500 companies leveraging its deep local expertise, streamlined technology and intelligent insights that enhance patient outcomes, regulated devices and in vitro diagnostics.
We assist companies in the medical industry to smoothly sail the paradigm shift driven by new regulations, value-based models, product introductions and high-tech innovations. As the customer successfully navigates the evolving market dynamics by leveraging our extensive experience in developing diagnostic, monitoring and therapeutic devices, they gain commercial success, increased operational efficiency, ensure compliance and manage costs at ideal levels. We provide full product lifecycle medical IT solutions where the process involves opportunity assessment, definition, conception, product development, verification, validation, product launch, commercialization, post-launch support, maintenance and patient feedback integration. We adhere to all standards of commercial, clinical, regulatory, technology and compliance in our Medtech services.



 Global
Global  United States
United States